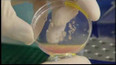
Škola pro buňky

27 minut

20. ledna 2010
Obsah dílu
Fascinující svět virtuální reality — Škola pro buňky — Úžasné katapulty
Části dílu
00:42

Fascinující svět virtuální reality
13:16
Škola pro buňky
14:54

Úžasné katapulty

Stopáž27 minut
27. ledna 2010
Přehled dílů
241 přehratelných

Stopáž28 minut
22. června 2012
O důležitosti vzdělávání
Poslední vysílání 22. 6. 2012 na ČT2

Stopáž27 minut
15. června 2012
Zpráva z konce světa — Obrazy mysli, mysl v obrazech
Poslední vysílání 15. 6. 2012 na ČT2

Stopáž27 minut
8. června 2012
Srážka vlaku s autem — Sleduj píp
Poslední vysílání 8. 6. 2012 na ČT2

Stopáž27 minut
1. června 2012
Kontroverzní éčka
Poslední vysílání 1. 6. 2012 na ČT2

Stopáž28 minut
25. května 2012
Molekuly mezi hvězdami — Dosušeno — Franklinovy zvonky
Poslední vysílání 25. 5. 2012 na ČT2

Stopáž28 minut
18. května 2012
FameLab 2012 – Národní finále — Virtuální tělo
Poslední vysílání 18. 5. 2012 na ČT2

Stopáž27 minut
11. května 2012
Roboty soutěžící i pracující — Příběh života
Poslední vysílání 11. 5. 2012 na ČT2

Stopáž28 minut
4. května 2012
EMOce ve vědě
Poslední vysílání 4. 5. 2012 na ČT2

Stopáž28 minut
27. dubna 2012
Hrozby pro planetu Zemi
Poslední vysílání 27. 4. 2012 na ČT2

Stopáž28 minut
20. dubna 2012
Fruktóza – a jed?
Poslední vysílání 20. 4. 2012 na ČT2



